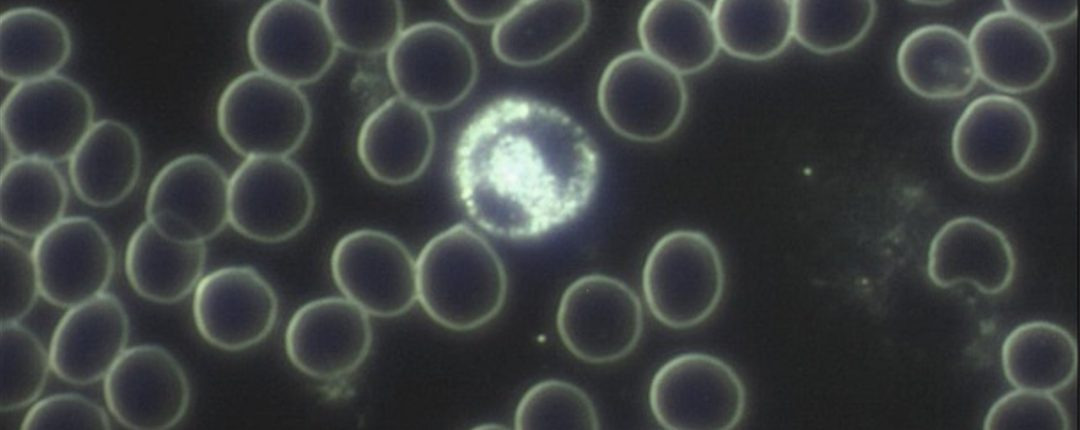

Alternative Diagnostik – Chancen und Grenzen
Alternative Diagnostik erklärt: Von Irisdiagnose bis Dunkelfeld – welche Verfahren wirklich helfen können und wo Vorsicht geboten ist.
Alternative Diagnostik – Chancen und Grenzen
Eine Diagnose kann erleichtern – oder belasten. Manche Patienten sind froh, wenn das Kind endlich einen Namen hat. Andere merken: Mit der Diagnose kommen neue Probleme hinzu.
Zwei Entwicklungen sind besonders kritisch:
Zum einen häufen sich Fehldiagnosen, wie ich in meinen Beiträgen zu immer mehr falschen Diagnosen oder röntgenologischen Fehldiagnosen in der Notaufnahme aufgezeigt habe. Zum anderen werden heute schlicht zu viele Diagnosen gestellt – oft schneller, als der Patient „guten Tag“ sagen kann.
Dabei sollte klar sein: Eine Diagnose ist kein Selbstzweck. Sie ist ein Werkzeug, um Leiden zu lindern und Heilung zu ermöglichen. Aristoteles nannte sie eine „besondere Erkenntnisform“ – und genau das ist sie: Erkenntnis, die in eine Therapie münden muss. Alles andere ist Etikettenschwindel.
Alternative Diagnoseverfahren
Die Naturheilkunde bietet hier spannende Ansätze. Neben den klassischen schulmedizinischen Tests nutzen Therapeuten alternative Verfahren, um Belastungen, Störungen und Ursachen aufzuspüren. Häufig eingesetzt werden zum Beispiel:
- Irisdiagnostik
- Kinesiologie
- Kirlianfotografie
- Pendeln
- Pulsdiagnostik
- Regulationsthermografie
- Dunkelfeldmikroskopie
- Haarmineralanalyse
- Bioelektronische Diagnoseverfahren
- CEIA Biodynamisches Eiweißprofil
Übrigens: Wenn Sie solche Informationen interessieren, dann fordern Sie unbedingt meinen Praxis-Newsletter mit den „5 Wundermitteln“ an:
Kleine Anmerkung: Die Sache mit den „5 Wundermitteln“ ist mit Abstand der beliebteste Newsletter, den meine Patienten gerne lesen…
IHRE FRAGEN
Einfach HIER klicken.
Registrieren und los geht´s!




